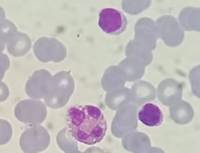
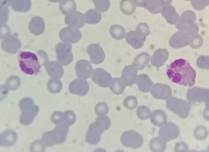

Síndrome hipereosinofílico idiopático infantil corticodependiente
Corticosteroid-dependent pediatric idiopathic hypereosinophilic syndrome
Lisazu Denis C; Sliba G; Do Santos S; Serralunga C; Serfaty L; Coronel A.
Servicio de Hematología y Hemoterapia, Hospital HIEMI. Mar del Plata, Buenos Aires, Argentina
Lisazu Denis https://orcid.org/0009-0006-8507-7577
Dra. Silvia Do Santos https://orcid.org/0009-0008-8960-5706
Dra. Anabella Coronel https://orcid.org/009-004-7670-3703
Dra. Gabriela Sliba https://orcid.org/0009-0005-6696-6558
Dra. Cecilia Serralunga https://orcid.org/0009-0001-1425-0188
Dra. Luz Serfaty https://orcid.org/0009-0008-6366-6156
carolinalisazudenis@hotmail.com
Palabras claves: síndrome hipereosinofílico idiopático/tratamiento farmacológico,
pediatría,
corticoides.
Keywords: idiopathic hypereosinophilic syndrome/pharmacological treatment,
pediatric,
corticosteroids.
Resumen
Paciente de 3 años de edad con retraso global del desarrollo, antecedente de desnutrición crónica, síndrome bronco obstructivo y síndrome hipereosinofílico idiopático (HES) corticodependiente de un año de evolución. Se descartan causas reactivas (infecciosas, medicamentosas, autoinmunes, inflamatorias, alérgicas, neoplásicas, endocrinológicas) y primarias clonales o familiares. Su corticodependencia plantea desafíos en el tratamiento a largo plazo. El paciente hoy se encuentra bajo tratamiento con meprednisona 0.75 mg/kg/día asociado con hidroxiurea 20 mg/kg/día con muy buena evolución.
Abstract
The aim of this report is to describe a 3-year-old patient with global developmental delay, history of chronic malnutrition, broncho-obstructive syndrome and idiopathic hypereosinophilic syndrome of one year of evolution. The most common causes of eosinophilia are discarded: reactive (drug induced, inflammatory, allergic, infectious, neoplastic disorders, autoimmune, endocrinopathy disease) and familial or clonal eosinophilia. His corticosteroid dependence poses treatment challenges. Today the patient is under treatment with meprednisone 0.75 mg/kg/day associated with hydroxyurea 20 mg/kg/day with good evolution.
Introducción
En condiciones fisiológicas se observan eosinófilos en tejidos linfoides, mucosa gastrointestinal y útero. En médula ósea (MO) representan un 1 a 6% de la celularidad, los cuales producen un recuento de eosinófilos en sangre periférica entre un 0.05 a un 0.5 x109/l. Su producción se encuentra controlada por factores de transcripción, citoquinas, IL5, IL3, factor estimulante de granulocitos macrófagos estimulado por linfocitos T activados, mastocitos y células estromales(1,2). Dichos factores aumentan en las eosinofilias reactivas. En la activación marcada y prolongada pueden migrar a otros órganos como piel, corazón y pulmones, causando daño.
Las causas de hipereosinofilias mayormente descritas son las reactivas. En Latinoamérica las enteroparasitosis representan 45%, seguidas por las medicamentosas, las alérgicas, autoinmunes, inflamatorias, endocrinológicas, neoplásicas con eosinofilia no clonal (15% de linfomas de Hodgkin), linfoproliferativas y variantes linfocíticas cuyo tratamiento es dirigido a la causa que la ocasiona.
Como eosinofilia (Eo) clonal, son descritas la neoplasia mieloide o linfoide. Se genera por fusión de genes que codifican para tirosinas kinasas que comprometen el receptor alfa y beta del factor de crecimiento de plaquetas (PDGFRA y PDGFRB respectivamente) o el receptor del factor de crecimiento (FGFR) fibroblástico. También se observan descriptas neoplasias mieloides crónicas, síndromes mieloproliferativos, leucemias mieloides agudas con tr(8,21), inversión del 16 y leucemias linfoblásticas agudas.
Sólo una vez descartadas las causas anteriormente descritas, tanto reactivas, clonales como familiares, será considerada la sospecha diagnóstica de síndrome hipereosinofílico de origen idiopático. Dicho trastorno se halla caracterizado por una elevación sustancial y persistente de eosinófilos y sus mediadores, desencadenando infiltración multisistémica, daño de órgano y gran variedad de manifestaciones clínicas, tales como erupción cutánea, nefritis, neumonitis, manifestaciones pleuropulmonares, hepatitis, vasculitis, mialgias, neuropatía, cardiopatía, etc.(1).
Las definiciones de hipereosinofilia y síndrome hipereosinofilico(1-7) se basan en la propuesta de Chusid de 1975, que se basa en los siguientes criterios: recuento de eosinófilos mayor o igual a 1500, que persiste más de 6 meses, de causa desconocida y asociada a signos de compromiso y/o disfunción de órgano.
Su incidencia y prevalencia es actualmente desconocida. No existe un consenso del RAE en sangre periférica para el cual el tratamiento sea necesariamente obligatorio en pacientes asintomáticos. El RAE no se correlaciona con el nivel de riesgo de daño de órgano, siendo indicación de tratamiento el daño de órgano independientemente del recuento de eosinófilos.
Las metas terapéuticas son reducir el RAE y mantener un nivel prudencial menor a 1.000/mm3(2), en función de reducir la infiltración en los tejidos y controlar el daño.
· En casos de tratamiento de emergencia se indica 1 mg/kg/día de metilprednisolona endovenosa(2).
· Como terapia de primera línea se indica prednisona.
· Con FIP1L1/PDGFRA positivos imatinib 100 a 400 mg/día.
· Los agentes de segunda línea son hidroxiurea e interferón α.
· En enfermedad refractaria están indicados los inmunomoduladores, como ciclosporina, con pobre eficacia y tolerancia, y azatioprina, reservado para casos de miositis o cardiopatía asociada(2). También se describen los anticuerpos monoclonales anti Il5 alemtuzumab y mepolizumab, entre otros(2).
· En HES idiopáticos refractarios aun documentando FIP1L1/PDGFRA negativos de podría realizar una prueba terapéutica corta con imatinib 100-400 mg diarios por un período de 4 a 6 semanas y evaluar respuesta(4,6).
· El trasplante de MO está indicado para pacientes con progresión de enfermedad a pesar de las terapias convencionales(3).
Dada la baja incidencia y prevalencia de dicha entidad en la población mundial, siendo más frecuente la aparición en la población adulta junto con la pobre evidencia bibliográfica de tratamientos efectivos de segunda línea en la población pediátrica, es de nuestro interés compartir la presentación de un caso de síndrome hipereosinofílico idiopático en seguimiento por el Servicio de Hematología de un Hospital Materno Infantil de nivel III de la Provincia de Buenos Aires.
Materiales y métodos
Reporte de caso
Paciente de 3 años de edad con retraso global del desarrollo, antecedente de desnutrición crónica y síndrome bronco obstructivo. Abuelos maternos consanguíneos. Sin alteraciones hematológicas familiares.
En mayo 2023 es derivado por Eo severa, deposiciones semidesligadas, síndrome febril y dolor abdominal. Como datos positivos al ingreso presenta un hemograma con anemia normocítica normocrómica, leucocitosis con neutrofilia, linfocitosis y eosinofilia severa, con plaquetas normales. Hemoglobina (Hb): 9.6 gr/dL, hematocrito (Hto): 29%, volumen corpuscular medio (VCM): 76 fl, CHCM: 35 gr/dL, glóbulos blancos (Gb): 40.800/mm3, neutrófilos segmentados (Ne): 30%, eosinófilos (Eos): 50%, recuento absoluto de eosinófilos (RAE): 20.400/mm3, linfocitos (Li): 20%, plaquetas 250.000/mm3. En el frotis los eosinófilos presentaban núcleos polilobulados y vacuolas en su interior. Eritrosedimentación (ERS): 100 mm. PCR 129 mg/L. Serología positiva para Toxocara canis. IgE dentro de límites normales. Se realiza seguimiento y controles con Infectología, descartándose cuadro de síndrome de larva migrans. Panel inmunohematológico negativo. Se solicita estudio de exoma para pesquisa de inmunodeficiencias. Resultado pendiente.

Punción aspirativa de médula ósea (PAMO) Serie megacariocítica presente, celularidad conservada. Serie eritroide: 26%, mieloide: 63%, linfoide: 11%. Citometría de flujo (CF): sin blastos. Eosinófilos: 67.1%. Estudio genético: negativo para mutaciones asociadas a eosinofilia. Estudio citogenético 46XY.


Videoendoscopía alta con biopsia: infiltración eosinofílica del 50% en antro gástrico y duodeno. Se descarta eosinofilia de origen alérgico dada la indemnidad de la mucosa. Por otra parte, se realiza test del sudor por contexto de diarreas y cuadro broncobstructivo recurrente, con resultado negativo. Inicia meprednisona 2 mg/kg/día por un mes y con RAE 1.910/mm3 se suspende glucocorticoide y se cita a control al mes.
Al mes de haber suspendido tratamiento, presenta RAE: 5.220/mm3 por lo que reinicia meprednisona 1 mg/kg/día vía oral. Con laboratorio control a los 11 días y RAE en descenso se decide descender glucocorticoide para evitar efectos adversos a largo plazo hasta suspenderlo y asociar hidroxiurea a 15 mg/kg/día vía oral como ahorrador de glucocorticoide. Se cita al paciente cada 10 días para evaluar curva de descenso de RAE. En los controles posteriores el paciente comienza a desmejorar, presentando anemia con requerimiento transfusional, RAE: 5.600/mm3, ERS y PCR en ascenso, agrega síndrome febril intermitente y compromiso respiratorio. Se diagnostica neumonía unifocal izquierda. Se realizaron hemocultivos, que fueron negativos, y aspirado para gérmenes comunes y COVID. que fue negativo. Se realiza TAC de tórax donde se observa imagen compatible con neumopatía infiltrativa. Se realiza lavado broncoalveolar, observándose infiltrado eosinofílico 60% con cultivo negativo para Aspergilosis asociada a eosinofilia en contexto de tratamiento inmunosupresor.
.



Durante la internación se realiza nueva PAMO con 17.1% de eosinófilos y biopsia con relación adiposo/hematopoyético 20/80%. Relación mieloide/eritroide 4:1. Serie megacariocítica conservada en número, forma y maduración. Serie eritroide conservada. Serie mieloide 30% a expensas de eosinófilos. Trama reticulínica conservada. Inicia corticoides orales a 2 mg/kg/día por dos meses con hidroxiurea 30 mg/kg/día, logrando respuesta completa. Inicia descenso lento de glucocorticoide en dos meses con la meta de monoterapia con hidroxiurea.
En marzo 2024, al presentar Gb: 17.000/mm3, RAE: 7.180/mm3 en monoterapia con hidroxiurea a dosis plena se decide suspender medicación para reevaluación de daño. La evaluación cardiológica es normal, mientras que la evaluación pulmonar tomográfica muestra un nuevo nódulo pulmonar en segmento basal de lóbulo superior intraparenquimatoso y una imagen inferior de 4 mm no biopsiable. Se realiza BAL, sin eosinofilia.


Se realiza RMN de cerebro. No se observan alteraciones. Se realiza tratamiento con imatinib 100 mg/día por 7 días sin respuesta (RAE: 7.440/mm3).
Desde abril 2024 se encuentra en tratamiento con meprednisona a la menor dosis posible en función de sostener recuentos de eosinófilos menor a 1.000 e hidroxiurea a la mayor dosis tolerada.
Discusión
En la actualidad existen escasos reportes de síndrome hipereosinofílico idiopático infantil. El glucocorticoide es el tratamiento de primera línea con respuesta excelente. No hay consenso acerca del mejor esquema terapéutico a largo plazo. La corticodependencia es un problema, dado los efectos adversos, sobre todo en un niño en crecimiento. Existen reportes de casos en la infancia con el uso combinado de hidroxiurea junto con glucocorticoide como ahorrador del mismo y en función de mantener niveles prudenciales de eosinófilos en sangre periférica. También son descritos otros medicamentos como agentes alquilantes, otros mielosupresores y anticuerpos monoclonales con riesgo de neoplasias secundarias, fibrosis pulmonar, o no aprobados para los infantes, con escasa tasa de respuesta. En nuestro caso el paciente se encuentra actualmente con un esquema combinado de hidroxiurea y corticoide, con mejoría y sin daño de órgano. Nuestra meta terapéutica es la de sostener un recuento de eosinófilos menor a 1x109/L en sangre periférica a dosis mínimas necesarias de meprednisona por dos a tres meses junto con hidroxiurea en ascenso, y luego realizar reducción gradual del corticoide hasta suspenderlo.
Bibliografía
1- Fischman Laura A y col. Síndrome Hipereosinofílico. HEMATOLOGÍA. 2007;11(3):220-242.
2. Butt NM, Lambert J, Ali S et al; British Committee for Standards in Haematology. Guideline for the investigation and management of eosinophilia. Br J Haematol. 2017 Feb;176(4):553-572. doi: 10.1111/bjh.14488.
3, Mikhail ES, Ghatol A. Hypereosinophilic Syndrome. 2024 Jan 11. In: StatPearls [Internet]. Treasure Island (FL): StatPearls Publishing; 2024 Jan–.
4. Klion AD. How I treat hypereosinophilic syndromes. Blood. 2015 Aug 27;126(9):1069-77. doi: 10.1182/blood-2014-11-551614.
5. Roufosse FE, Goldman M, Cogan E. Hypereosinophilic syndromes. Orphanet J Rare Dis. 2007 Sep 11;2:37. doi: 10.1186/1750-1172-2-37.
6. Klion AD, Bochner BS, Gleich GJ et al; The Hypereosinophilic Syndromes Working Group. Approaches to the treatment of hypereosinophilic syndromes: a workshop summary report. J Allergy Clin Immunol. 2006 Jun;117(6):1292-302. doi: 10.1016/j.jaci.2006.02.042.
7. Klion A. Hypereosinophilic syndrome: approach to treatment in the era of precision medicine. Hematology Am Soc Hematol Educ Program. 2018 Nov 30;2018(1):326-331. doi: 10.1182/asheducation-2018.1.326.
8. Hwee J, Huynh L, Du S et al. Hypereosinophilic syndrome in Europe: Retrospective study of treatment patterns, clinical manifestations, and healthcare resource utilization. Ann Allergy Asthma Immunol. 2023 Jun;130(6):768-775. doi: 10.1016/j.anai.2023.02.022.